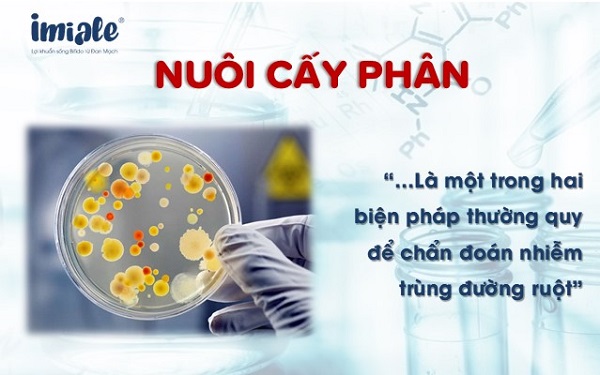
nuôi cấy phân để chẩn đoán nhiễm trùng đường ruột

Nhiễm trùng đường ruột hay nhiễm khuẩn đường ruột là một trong những bệnh nhiễm khuẩn có tỷ lệ tử vong cao ở trẻ em. Bài viết dưới đây sẽ giới thiệu cho mẹ những điều cần biết để nhận biết và chăm sóc cho con khi con có dấu hiệu mắc bệnh.
Mục lục
1. Nhiễm trùng đường ruột ở trẻ là gì?
Nhiễm trùng đường ruột là nhiễm trùng do vi rút, vi khuẩn hoặc ký sinh trùng gây ra viêm dạ dày – ruột, tình trạng viêm đường tiêu hóa liên quan đến cả dạ dày và ruột non. Đây là một bệnh khá phổ biến, có thể gặp ở mọi lứa tuổi và hay gặp nhất là ở trẻ em. Bệnh chủ yếu lây nhiễm thông qua đường ăn uống do thực phẩm không đảm bảo vệ sinh. Mức độ nghiêm trọng của bệnh sẽ phụ thuộc vào tình trạng nhiễm trùng.
Có ba nguyên nhân chính gây nhiễm trùng đường ruột ở trẻ:
1.1. Nguyên nhân gây nhiễm trùng đường ruột do vi khuẩn.
Các nguồn nhiễm trùng đường tiêu hóa do vi khuẩn phổ biến bao gồm: Salmonella, Escherichia coli (E. coli), Clostridium perfringens, Listeria, Staphylococcus (tụ cầu), Campylobacter
1.2. Nguyên nhân gây nhiễm trùng đường ruột do virus
Nhiễm trùng đường ruột do vi rút rất phổ biến, thường gặp do: Norovirus, Rotavirus, Adenovirus
1.3. Nhiễm trùng đường ruột do ký sinh trùng.
Ký sinh trùng gây bệnh phổ biến nhất là Giardia và Cryptosporidiosis.
2. Triệu chứng nhiễm trùng đường ruột ở trẻ
Hầu hết các bệnh nhiễm trùng đường ruột đều có các triệu chứng giống nhau, mặc dù chúng có thể khác nhau về mức độ nghiêm trọng.
2.1. Các triệu chứng của nhiễm trùng đường ruột bao gồm:
- Tiêu chảy
- Buồn nôn, nôn
- Nôn mửa
- Co thắt dạ day
- Ăn không ngon, chán ăn
- Sốt
- Đầy hơi và chướng bụng
- Sút cân
Hầu hết các bệnh nhiễm trùng đường ruột do vi rút khởi phát đột ngột và kéo dài dưới một tuần, hoặc ngoại lệ có thể kéo dài lâu hơn.
Nhiễm trùng do vi khuẩn có thể có biểu hiện tương tự như nhiễm vi rút, nhưng một số có thể có nhiều khả năng gây sốt cao hoặc tiêu chảy ra máu.
Nhiễm ký sinh trùng đường ruột thường gây tiêu chảy ra máu hoặc có chất nhầy.
» Xem thêm: Bé đi ngoài ra máu có nguy hiểm không?
2.2. Cha mẹ cần đưa trẻ đến gặp bác sỹ nếu có những dấu hiệu sau
- Sốt trên 39°C
- Trẻ có biểu hiện hôn mê
- Thường xuyên cáu kỉnh
- Tiêu chảy ra máu
- Mất nước kéo dài, khóc không ra nước mắt
3. Chẩn đoán nhiễm trùng đường ruột ở trẻ
Các bác sỹ sẽ căn cứ dựa vào tình trạng của trẻ, yếu tố dịch tễ và các xét nghiệm chuyên khoa để chẩn đoán xác định nhiễm trùng đường ruột ở trẻ. Cha mẹ không nên tự ý sử dụng thuốc trước khi hỏi ý kiến của cán bộ y tế. Vì hành động này có thể làm mất các dấu hiệu điển hình, góp phần chẩn đoán chính xác bệnh và mức độ nghiêm trọng mà trẻ mắc phải. Ngày nay, các cơ sở y tế sử dụng phổ biến nhất 2 xét nghiệm để chẩn đoán cận lâm sàng:
- Nuôi cấy phân
- Phát hiện kháng nguyên từ mẫu phân
Trong một số trường hợp nhất định (ví dụ như đối với vi khuẩn E. coli, Salmonella,…), xét nghiệm tính nhạy cảm của kháng sinh được sử dụng để xác định sự kháng thuốc của vi sinh vật từ đó tìm ra nguyên nhân cụ thể.
4. Phác đồ điều trị nhiễm trùng đường ruột ở trẻ
Nhiễm trùng đường ruột ở trẻ có nguy hiểm không? Trong hầu hết các trường hợp, khi trẻ mắc bệnh ở mức độ nhẹ cơ thể sẽ tự hồi phục khi có chế độ chăm sóc và ăn uống sinh hoạt thích hợp.
4.1. Bù nước
Khi trẻ bị nhiễm trùng đường ruột cha mẹ cần chú ý theo dõi để bổ sung nước cho con, tránh để mất nước kéo dài có thể gây nguy hiểm. Biện pháp đơn giản nhất là bù nước bằng đường uống. Cha mẹ có thể bù bằng nước hoặc các chất lỏng khác như sữa mẹ, sữa công thức, cháo loãng, dung dịch Oresol,…
- Đối với những trẻ dưới 2 tuổi thì lượng oresol đưa vào cơ thể là 50-100ml.
- Trẻ trên 2 tuổi uống 100-200ml sau mỗi lần đi ngoài.
Trong trường hợp không thể bù nước bằng đường uống, trẻ cần được đưa đến cơ sở y tế để được theo dõi và thực hiện tiêm truyền qua đường tĩnh mạch.
» Xem thêm: 10 điều mẹ cần biết khi trẻ bị tiêu chảy
4.2. Sử dụng thuốc kháng sinh
Thuốc kháng sinh thường không được khuyến khích sử dụng vì chúng không có tác dụng đối với các bệnh nhiễm vi rút. Mặt khác thuốc kháng sinh có thể gây ra các tác dụng không mong muốn, lạm dụng làm tăng nguy cơ vi khuẩn kháng thuốc phát triển.
Mặc dù kháng sinh có thể giúp điều trị các trường hợp nhiễm vi khuẩn, ký sinh trùng phức tạp, nhưng trong những trường hợp bệnh không biến chứng, kháng sinh thực sự có thể kéo dài tình trạng bệnh và tăng nguy cơ tái phát.
Cha mẹ hết sức lưu ý, chỉ sử dụng thuốc kháng sinh khi có chỉ định của bác sỹ có chuyên môn.
Một số loại thuốc kháng sinh được sử dụng trong trường hợp trẻ bị nhiễm trùng đường ruột:
- AZITHROMYCIN (điều trị bệnh nhiễm Salmonella): 20 mg/kg (tối đa 1 g) ngày uống 1 lần, uống trong 5 – 7 ngày
- METRONIDAZOLE (điều trị viêm ruột do lỵ amip): 30 mg/kg/ngày chia 2 lần.
- CEFIXIME (điều trị lỵ do Shigella nhạy cảm, thương hàn do Salmonellatyphi). Trẻ trên 6 tháng tuổi – 12 tuổi: liều 8 mg/kg/ngày, chia 2 lần, mỗi lần cách nhau 12 giờ. Tuỳ thuộc loại nhiễm khuẩn, nên kéo dài thêm 48 – 72 giờ sau khi các triệu chứng nhiễm khuẩn đã hết.
- ERYTHROMYCIN (điều trị viêm ruột do Campylobacter): 30 – 50 mg/kg/ngày, chia 2 – 4 lần. Trong trường hợp nhiễm khuẩn nặng, liều có thể tăng lên gấp đôi, nhưng không vượt quá 4 g/ngày. Chú ý khi dùng liều trên 1g/ngày phải chia đều liều uống ít nhất làm 3 lần.
- CIPROFLOXACIN (điều trị nhiễm khuẩn do Salmonella, Shigella): Không khuyến cáo dùng cho trẻ em và thiếu niên (dưới 18 tuổi), nhưng khi thật cần thiết, có thể cho uống hoặc tiêm truyền tĩnh mạch trong 60 phút.
Đối với trẻ nhỏ tuổi, BNFC – Dược thư Quốc gia Anh dành cho trẻ em khuyến cáo dùng liều sau:
- Sơ sinh: 15 mg/kg uống hoặc 10 mg/kg truyền tĩnh mạch, uống hoặc tiêm ngày 2 lần.
- Từ 1 tháng tuổi – 18 tuổi: 20 mg/kg (tối đa 750 mg) uống ngày 2 lần hoặc 10 mg/kg (tối đa 400 mg) 3 lần mỗi ngày.
Xem thêm: 4 nhóm thuốc sử dụng khi trẻ bị tiêu chảy
4.3. Điều chỉnh chế độ ăn để điều trị nhiễm trùng đường ruột
Chế độ ăn uống hợp lý và đầy đủ dinh dưỡng sẽ giúp cơ thể bé có nhiều năng lượng và mau chóng hồi phục.
- Chia nhỏ bữa ăn trong ngày, thức ăn cần được làm mềm để trẻ có thể dễ tiêu hóa hơn
- Cho trẻ uống nhiều nước, sữa,..
- Tránh sử dụng các thực phẩm gây khó tiêu như bắp cải, súp lơ,..
- Tránh đồ ăn cay nóng
- Không sử dụng đồ uống có gas
- Uống và ăn thêm hoa quả tươi để cung cấp thêm các vitamin và muối khoáng.
![]()
- Bổ sung thêm men tiêu hóa từ thực phẩm (giá đỗ, các hạt nảy mầm,..) hoặc men vi sinh nhất là khi trẻ đang trong quá trình sử dụng thuốc kháng sinh
- Khi trẻ mắc nhiễm trùng đường ruột, các chuyên gia của Viện Dinh dưỡng Quốc gia khuyên mẹ nên sử dụng cho con những loại thực phẩm sau:
- Gạo, khoai tây, các loại rau quả có màu vàng và đỏ, xanh thẫm, giá đỗ xanh.
- Thịt gà, bò, thịt thăn lợn, trứng, sữa.
- Dầu thực vật, mỡ gà, mỡ lợn.
- Các loại quả tươi: Cam, bưởi, chuối, xoài, đu đủ, nước dừa…
5. Dự phòng nhiễm trùng đường ruột ở trẻ
Những cách tốt nhất để ngăn ngừa nhiễm trùng đường ruột ở trẻ bao gồm:
- Rửa tay cho trẻ đúng cách, đặc biệt trước khi ăn và sau khi đi vệ sinh.
- Khử trùng các bề mặt bị ô nhiễm bằng dung dịch khử trùng chuyên dụng.
- Thường xuyên vệ sinh đồ chơi của trẻ, giặt quần áo thường xuyên.
- Vệ sinh sạch sẽ nơi chế biến thực phẩm, không để lẫn đồ sống với đồ chín, bảo quản thực phẩm đúng cách.
- Lựa chọn thực phẩm tươi sạch, không nên ăn thức ăn để quá lâu.
- Sử dụng men vi sinh thường xuyên để hệ tiêu hóa của con luôn khỏe mạnh.
» Xem thêm: Nguyên tắc điều trị tiêu chảy nhiễm khuẩn cho trẻ sơ sinh
Nhiễm trùng đường ruột sẽ là bệnh nguy hiểm đối với trẻ nếu cha mẹ không nhận ra tình trạng đường tiêu hóa của con đang gặp vấn đề và có biện pháp xử trí kịp thời. Bổ sung Men vi sinh có thành phần từ lợi khuẩn sống thường xuyên nhằm hỗ trợ và cải thiện hệ tiêu hóa đường ruột của trẻ tránh khỏi các vấn đề này. Men vi sinh là người bạn đồng hành của cha mẹ để bảo vệ con trên con đường cùng con khôn lớn.
Để biết thêm thông tin chi tiết, vui lòng liên hệ với các chuyên gia của chúng tôi theo HOTLINE 1900 9482 hoặc 0967 629 482.